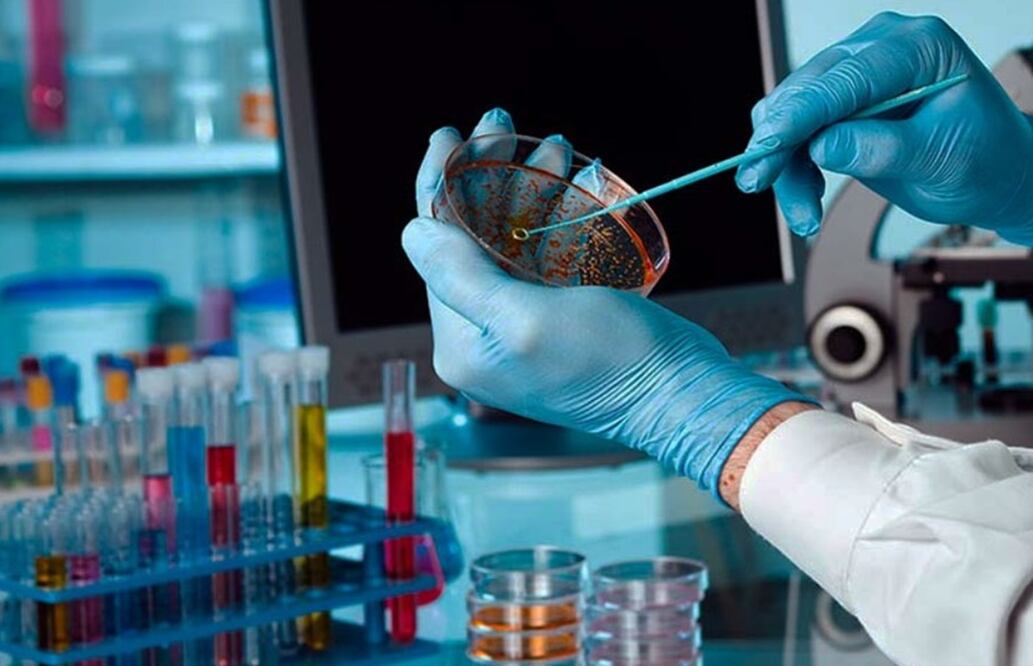
Foto: UNAM

Más Información
Investigadores del Instituto Sloan Kettering (Estados Unidos) han descubierto un nuevo "soldado" de células inmunitarias que podría ser un buen objetivo para la inmunoterapia contra el cáncer , según han informado a la revista "Nature".
Los científicos han reconocido que este hallazgo puede mejorar la brecha entre las personas que responden al tratamiento y las que no. Las nuevas células, que los científicos han denominado células T asesinas innatas , difieren de manera notable del objetivo convencional de muchas inmunoterapias: las células T citotóxicas.
Por un lado, no se agotan por la actividad prolongada como lo hacen las células T citotóxicas y pueden penetrar más profundamente en los tejidos donde se esconde el cáncer. "Creemos que estas células T asesinas innatas podrían ser el objetivo o modificarse genéticamente para la terapia contra el cáncer. Pueden ser mejores para alcanzar y matar tumores sólidos que las células T convencionales", ha asegurado Ming Li, autor principal del estudio.
Lee también:
En este nuevo estudio, han utilizado una variedad de técnicas, incluido el análisis de una sola célula y la edición del genoma CRISPR, para caracterizar aún más las células. Uno de los descubrimientos ha sido que las células T asesinas innatas no producen la molécula de punto de control inmunitario PD-1 y, como consecuencia, no parecen agotarse como lo hacen las células T asesinas típicas. Esta es una característica atractiva en una posible terapia con células inmunitarias.
"Las células también parecen reconocer diferentes marcadores, o antígenos, en las células cancerosas. Mientras que las células T asesinas convencionales reconocen antígenos mutados específicos (llamados neoantígenos), las células T asesinas de tipo innato reconocen una gama mucho más amplia de antígenos no mutados (es decir, normales)", han explicado los investigadores.
Las células T asesinas de tipo innato tampoco dependen de las células presentadoras de antígenos, como las células dendríticas, para alertarlas de la presencia de antígenos de aspecto peligroso. De esta forma, se comportan más como células inmunitarias innatas que siempre están preparadas y listas para el ataque.
Lee también:
melc
Noticias según tus intereses
[Publicidad]
[Publicidad]